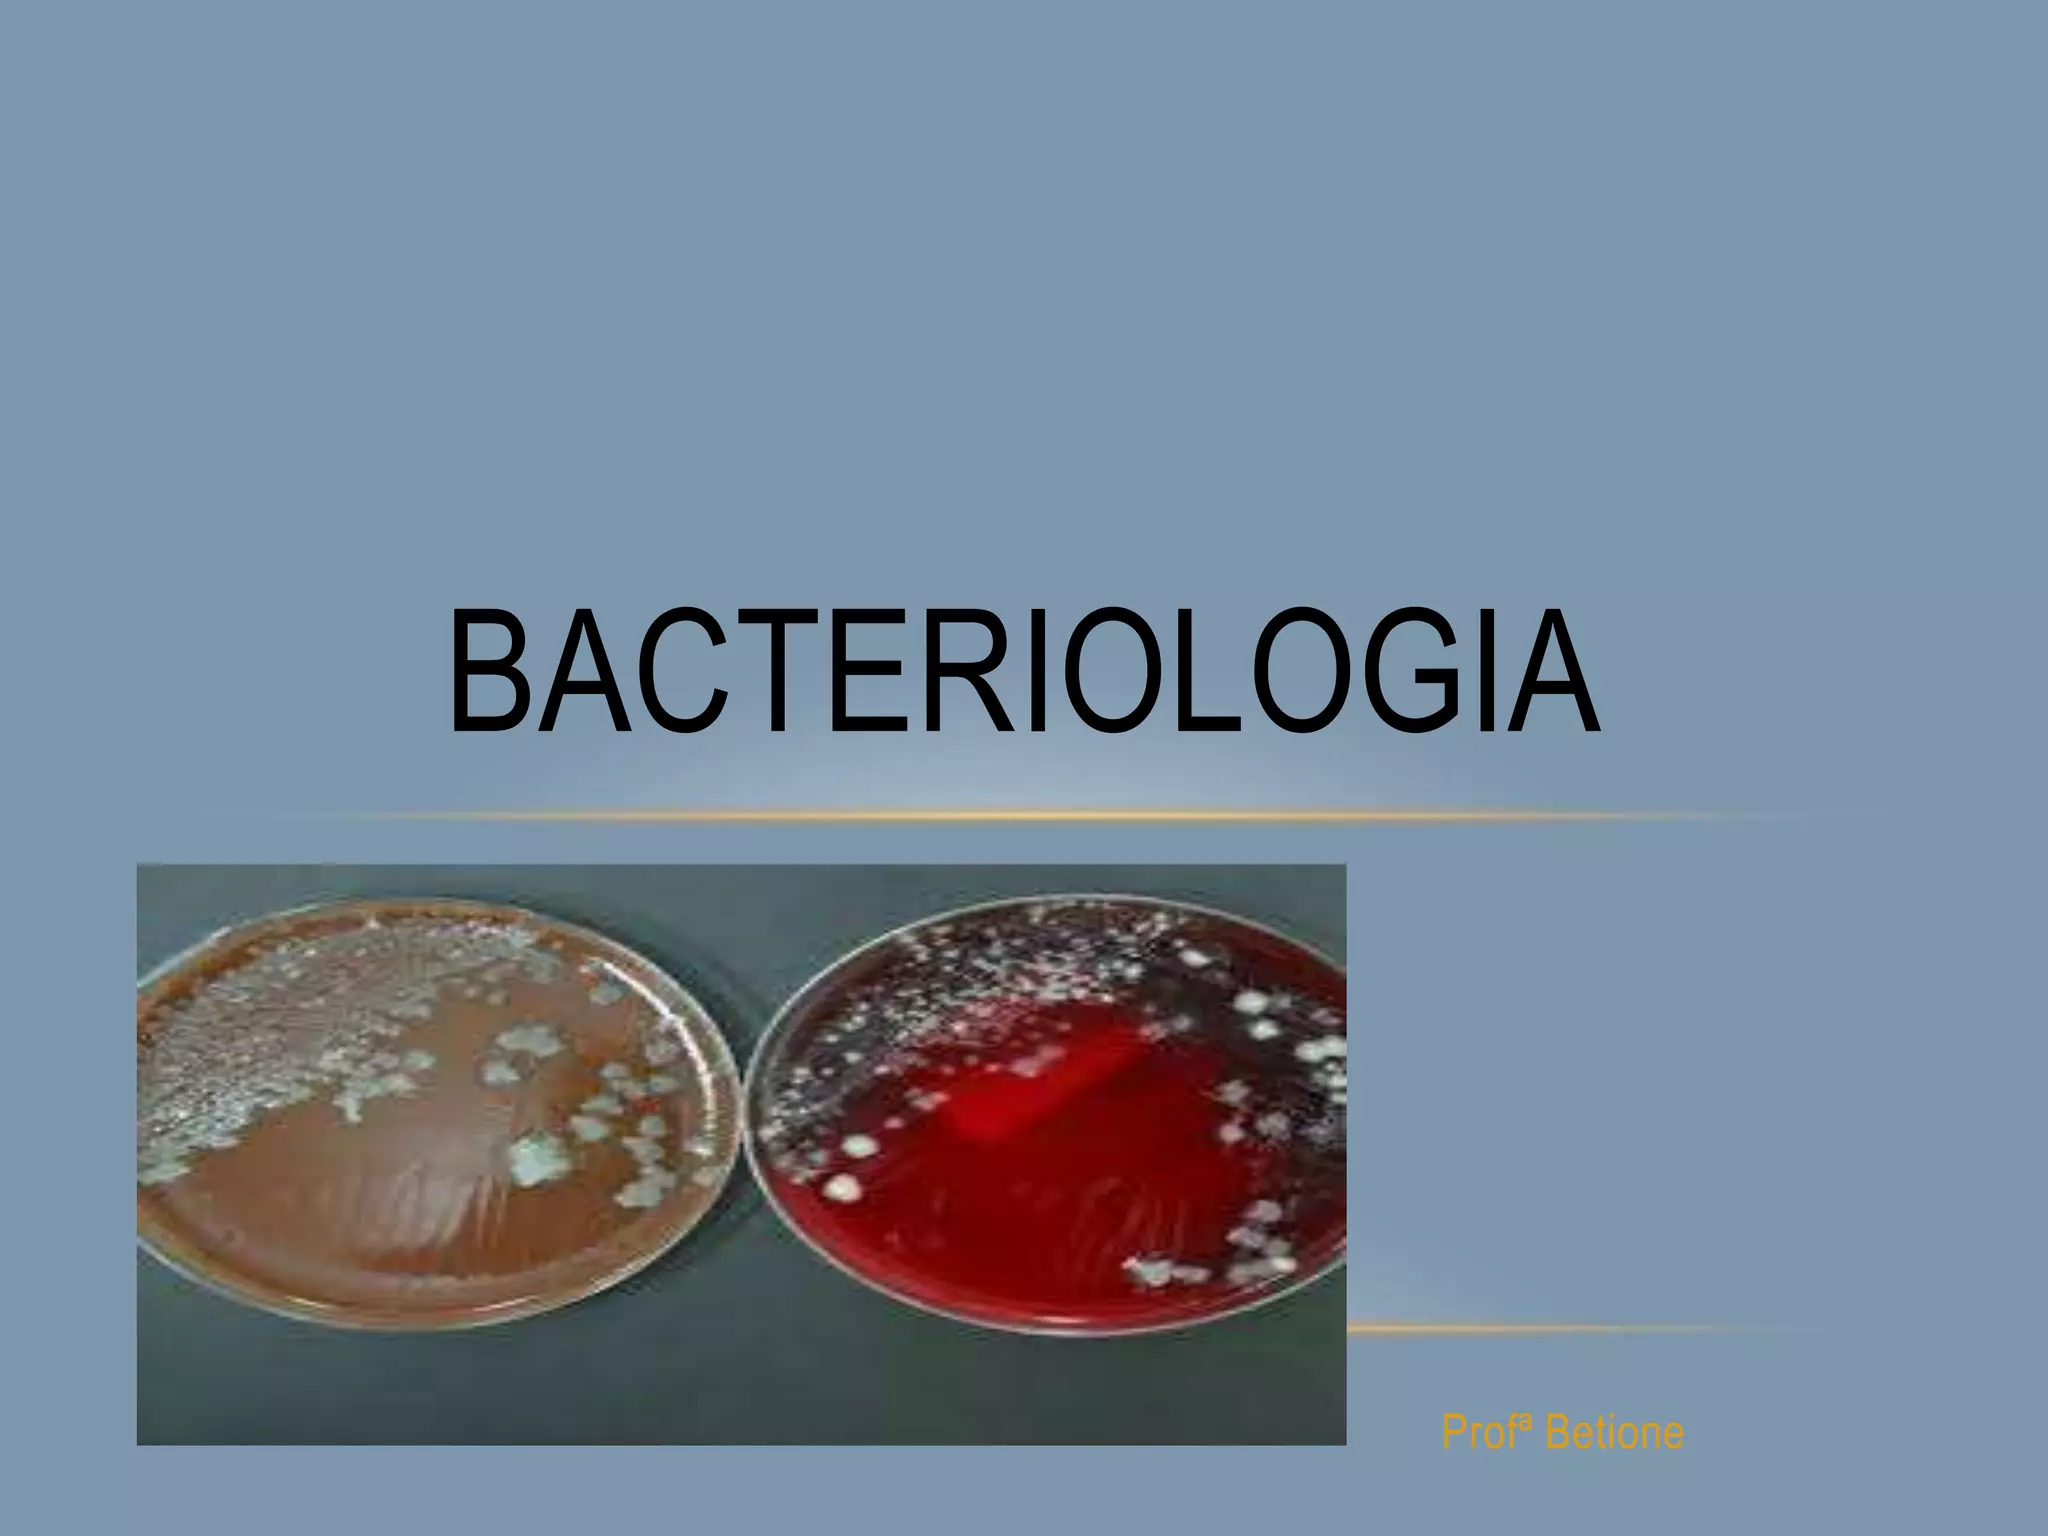
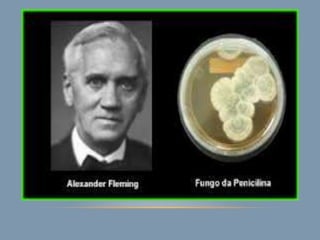

O documento discute o tópico de bacteriologia, definindo-a como o estudo das bactérias. Descreve as características gerais das bactérias, incluindo sua morfologia, estrutura celular, reprodução e classificação. Também aborda antibióticos, resistência bacteriana e as principais doenças causadas por bactérias.